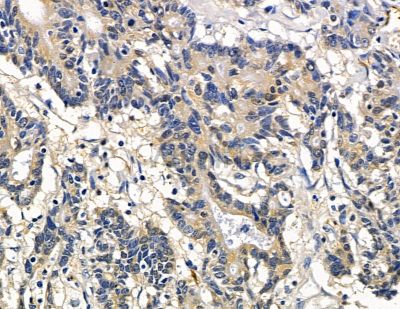
NHLRC2 Antibody - DF15989 at 1/100 staining human colorectal cancer and para-carcinoma tissue by IHC-P.

NHLRC2 Antibody - #DF15989
Related Downloads
Protocols
Product Info
*The optimal dilutions should be determined by the end user. For optimal experimental results, antibody reuse is not recommended.
*Tips:
WB: For western blot detection of denatured protein samples. IHC: For immunohistochemical detection of paraffin sections (IHC-p) or frozen sections (IHC-f) of tissue samples. IF/ICC: For immunofluorescence detection of cell samples. ELISA(peptide): For ELISA detection of antigenic peptide.
Fold/Unfold
1200003G01Rik; DKFZp779F115; FLJ20147; FLJ25621; FLJ33312; MGC45492; NHL repeat containing 2; NHL repeat-containing protein 2; NHLC2_HUMAN; NHLRC2; Novel NHL repeat domain containing protein; OTTHUMP00000020518;
Immunogens
A synthesized peptide derived from human NHLRC2.
Ubiquitous. Detected in heart, kidney, muscle, brain, lung, liver and in skin fibroblasts (at protein level).
- Q8NBF2 NHLC2_HUMAN:
- Protein BLAST With
- NCBI/
- ExPASy/
- Uniprot
MAAPGGRGRSLSGLLPAQTSLEYALLDAVTQQEKDSLVYQYLQKVDGWEQDLSVPEFPEGLEWLNTEEPISVYKDLCGKIVVLDFFTYCCINCIHLLPDLHALEHTYSDKDGLLIIGVHSAKFPNEKVLDNIKSAVLRYNITHPMVNDADASLWQELEVSCWPTLVILGPRGNMLFSLIGEGHKDKLFLYTSIALKYYKDRGQIRDNKIGIKLYKDSLPPSPLLFPGKVTVDQVTDRLVIADTGHHRILVVWKNGQIQYSIGGPNPGRKDGIFSESTFNSPQGVAIMNNIIYVADTENHLIRKIDLEAEKVSTVAGIGIQGTDKEGGAKGEQQPISSPWDVVFGTSGSEVQRGDILWIAMAGTHQIWALLLDSGKLPKKNELTKGTCLRFAGSGNEENRNNAYPHKAGFAQPSGLSLASEDPWSCLFVADSESSTVRTVSLKDGAVKHLVGGERDPMNLFAFGDVDGVGINAKLQHPLGVTWDKKRNLLYVADSYNHKIKVVDPKTKNCTTLAGTGDTNNVTSSSFTESTFNEPGGLCIGENGELLYVADTNNHQIKVMDLETKMVSVLPIFRSENAVVDGPFLVEKQKTLPKLPKSAPSIRLSPVTACAGQTLQFKLRLDLPSGSKLTEGVSSCWFLTAEGNEWLLQGQIAAGDIENISSQPTISLQIPDDCLSLEAIVSVSVFLYYCSADSSACMMKAILFSQPLQITDTQQGCIAPVELRYVF
Research Backgrounds
Required for normal embryonic development.
Cytoplasm>Cytosol.
Ubiquitous. Detected in heart, kidney, muscle, brain, lung, liver and in skin fibroblasts (at protein level).
Restrictive clause
Affinity Biosciences tests all products strictly. Citations are provided as a resource for additional applications that have not been validated by Affinity Biosciences. Please choose the appropriate format for each application and consult Materials and Methods sections for additional details about the use of any product in these publications.
For Research Use Only.
Not for use in diagnostic or therapeutic procedures. Not for resale. Not for distribution without written consent. Affinity Biosciences will not be held responsible for patent infringement or other violations that may occur with the use of our products. Affinity Biosciences, Affinity Biosciences Logo and all other trademarks are the property of Affinity Biosciences LTD.